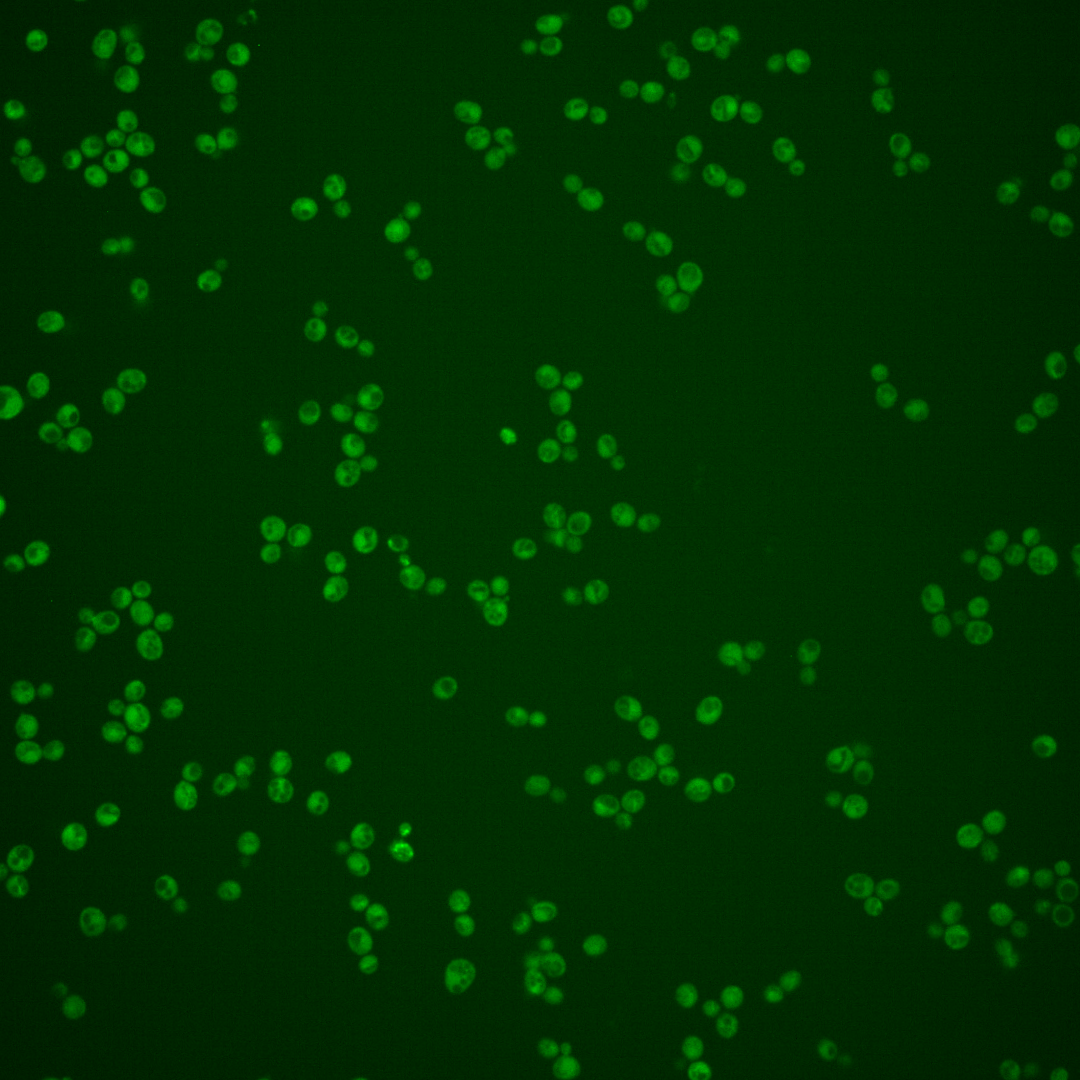
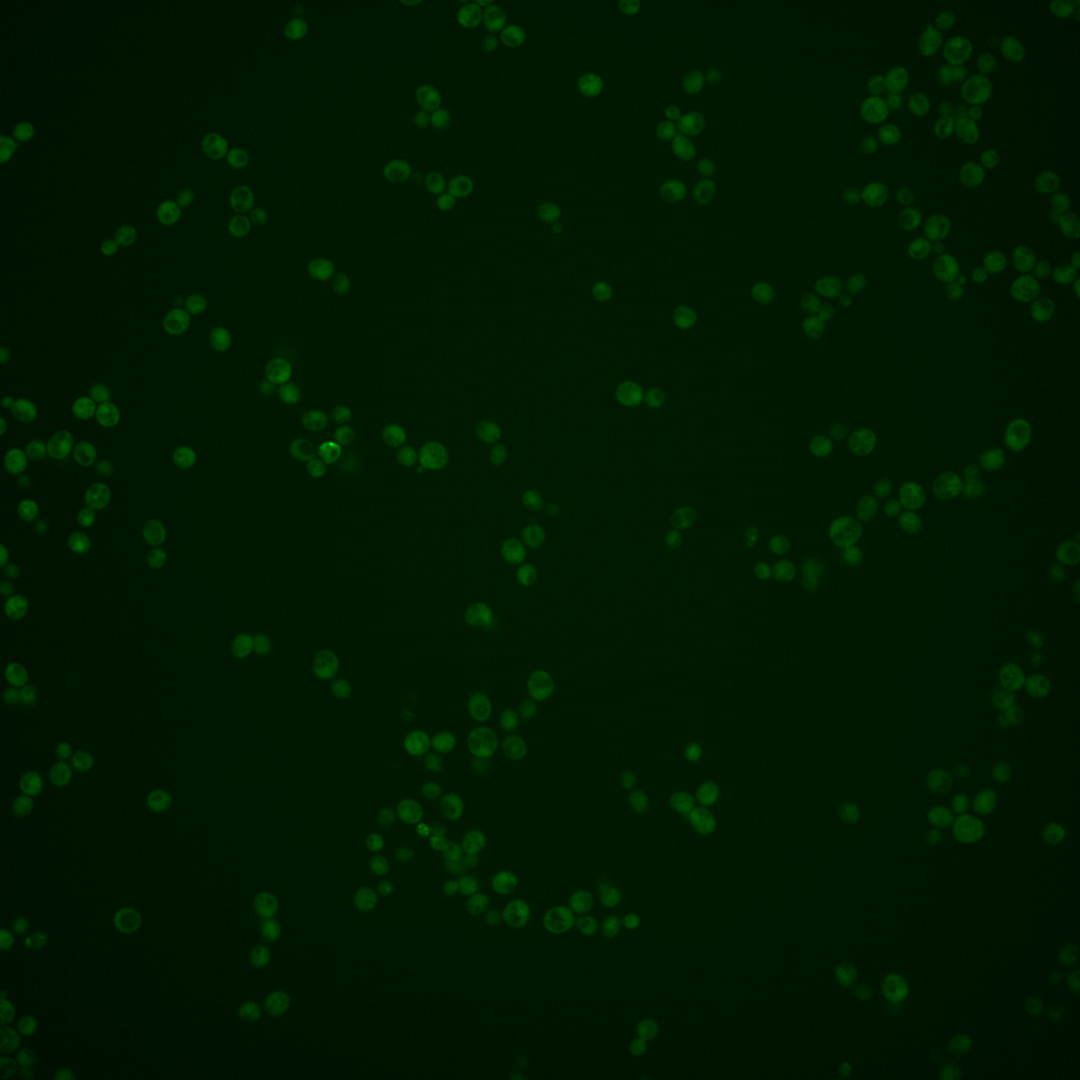
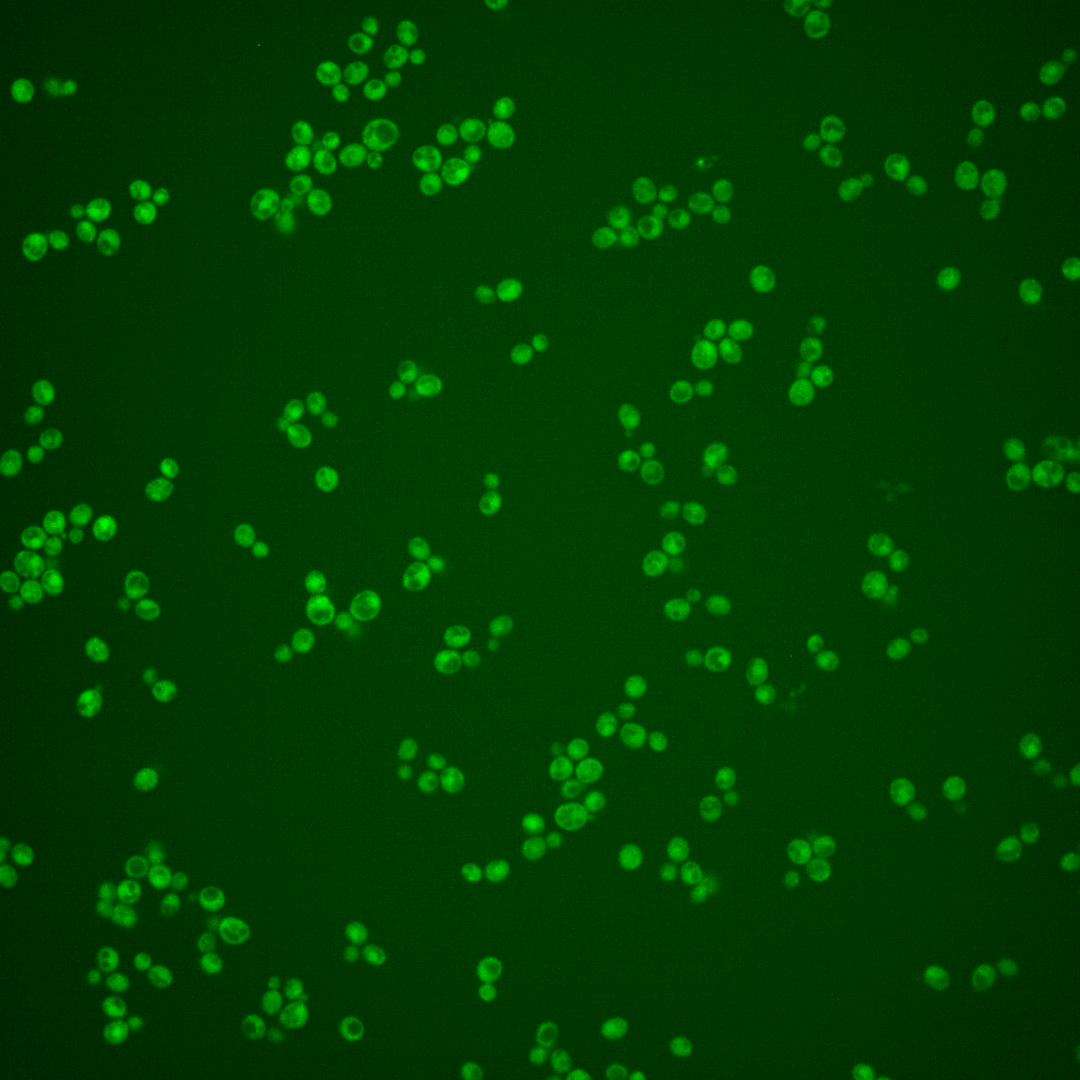
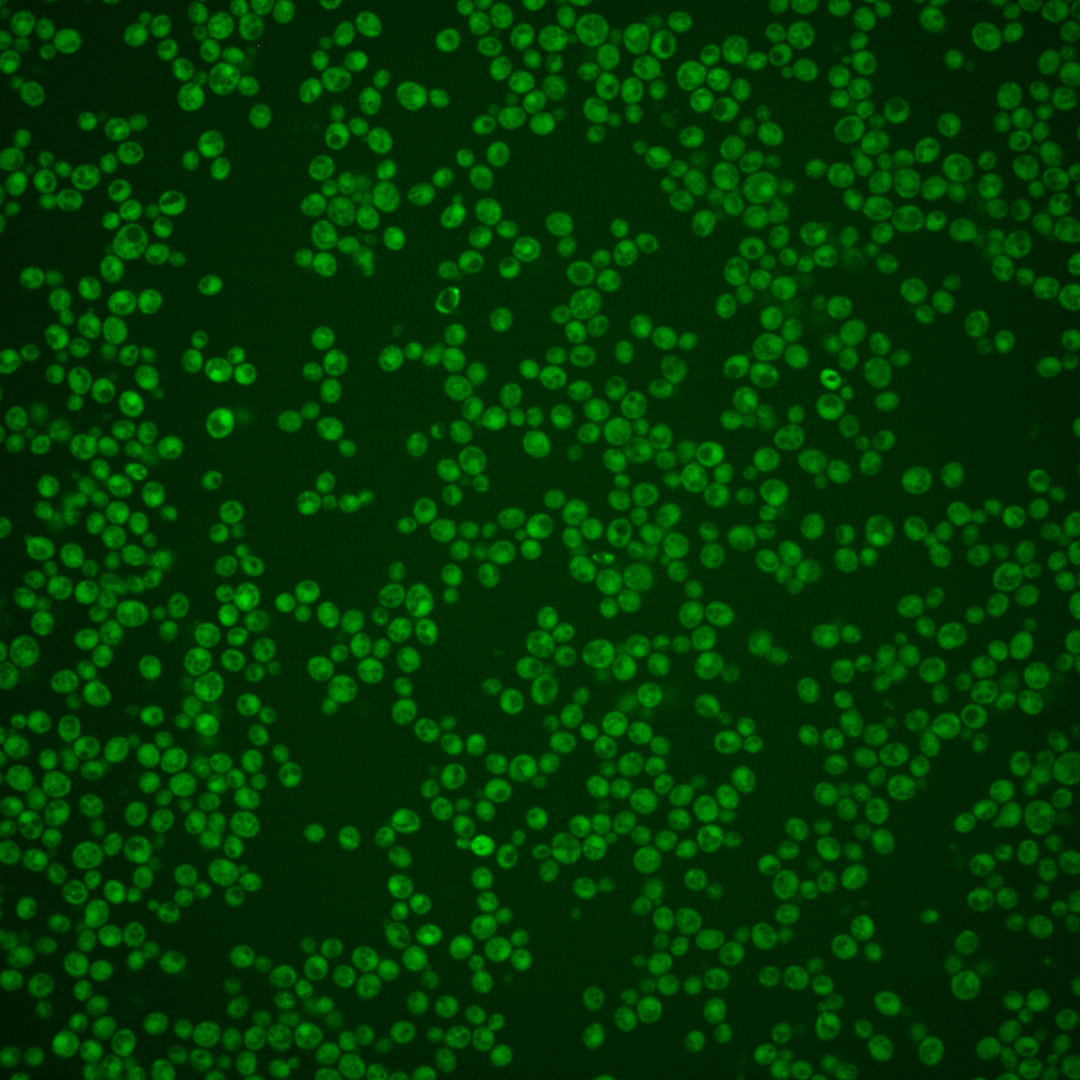
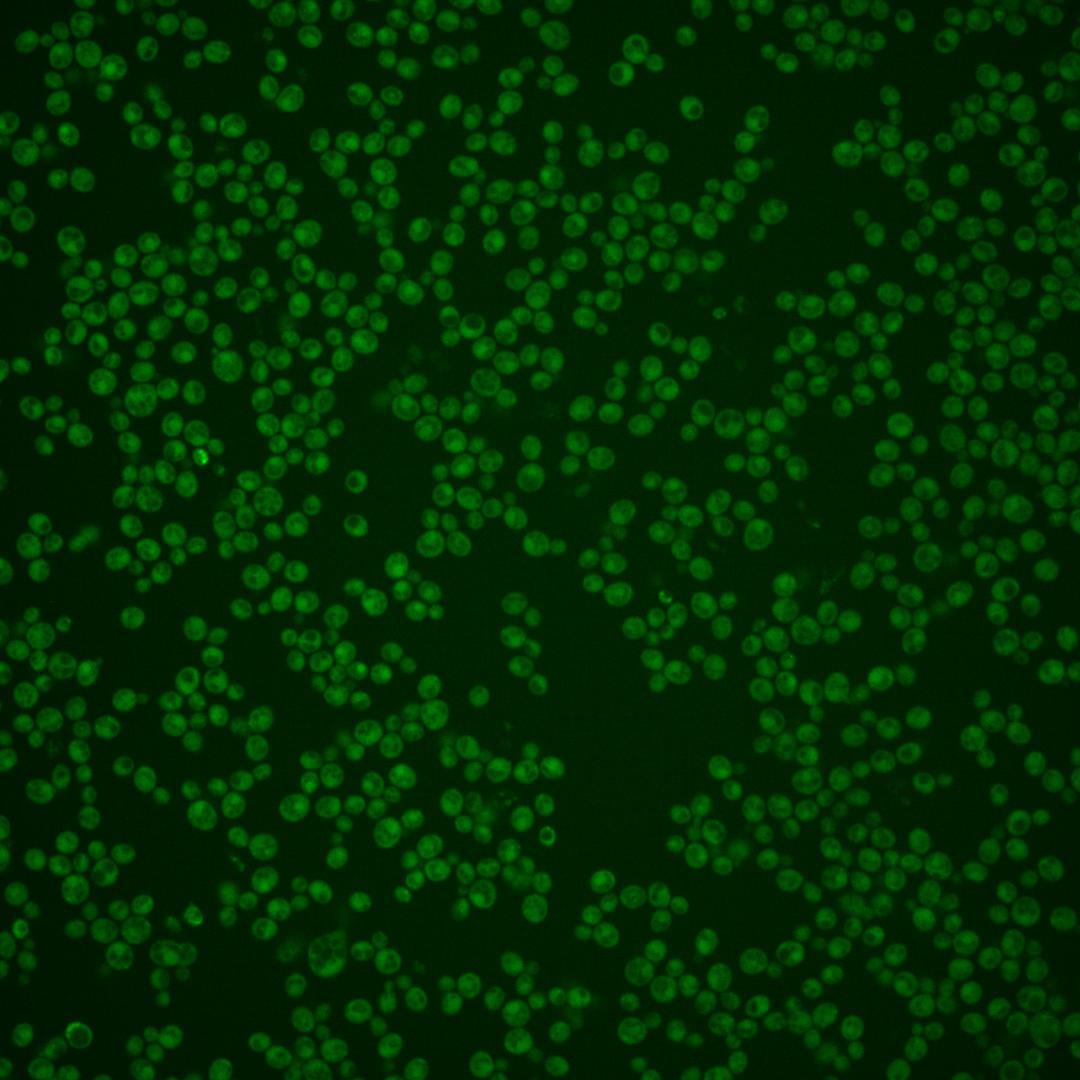

| Standard name | |
|---|---|
| Human Ortholog | |
| Description | Protein of unknown function; may have a role in lipid metabolism, based on localization to lipid droplets; predicted to be palmitoylated |
Micrographs




















































































Sub-cellular Localization
Yeast GFP Assignment
Protein Abundance
Localization Change
External localization resources
| ensLOC | DeepLoc | |||||||||||||||||||||||
|---|---|---|---|---|---|---|---|---|---|---|---|---|---|---|---|---|---|---|---|---|---|---|---|---|
| Localization | WT1 | WT2 | WT3 | RAP60 | RAP140 | RAP220 | RAP300 | RAP380 | RAP460 | RAP540 | RAP620 | RAP700 | HU80 | HU120 | HU160 | rpd3Δ_1 | rpd3Δ_2 | rpd3Δ_3 | WT1 | WT2 | WT3 | AF100 | AF140 | AF180 |
| Cortical Patches | 0 | 2 | 0 | 0 | 0 | 0 | 0 | 0 | 0 | 0 | 0 | 0 | 1 | 0 | 0 | 4 | 2 | 6 | 3 | 4 | 5 | 2 | 3 | 2 |
| Bud | 1 | 2 | 3 | 0 | 1 | 2 | 4 | 4 | 5 | 4 | 1 | 3 | 1 | 1 | 0 | 1 | 0 | 1 | 0 | 2 | 1 | 1 | 5 | 0 |
| Bud Neck | 0 | 0 | 0 | 0 | 0 | 0 | 0 | 0 | 1 | 0 | 0 | 0 | 0 | 0 | 0 | 0 | 0 | 0 | 1 | 6 | 1 | 2 | 1 | 4 |
| Bud Site | 0 | 0 | 0 | 0 | 0 | 0 | 0 | 0 | 1 | 0 | 0 | 0 | 0 | 0 | 0 | 0 | 0 | 0 | – | – | – | – | – | – |
| Cell Periphery | 0 | 3 | 1 | 1 | 1 | 0 | 2 | 0 | 1 | 1 | 1 | 2 | 0 | 3 | 3 | 0 | 2 | 2 | 0 | 1 | 0 | 0 | 1 | 0 |
| Cytoplasm | 172 | 276 | 143 | 99 | 125 | 108 | 156 | 137 | 95 | 98 | 66 | 84 | 333 | 460 | 384 | 283 | 140 | 161 | 134 | 238 | 77 | 139 | 207 | 175 |
| Endoplasmic Reticulum | 6 | 9 | 4 | 2 | 0 | 5 | 1 | 4 | 2 | 4 | 2 | 1 | 7 | 3 | 2 | 7 | 6 | 4 | 28 | 15 | 31 | 16 | 12 | 16 |
| Endosome | 0 | 0 | 3 | 0 | 3 | 1 | 4 | 1 | 0 | 0 | 1 | 1 | 0 | 4 | 1 | 9 | 1 | 14 | 2 | 2 | 6 | 1 | 6 | 4 |
| Golgi | 0 | 1 | 0 | 0 | 1 | 0 | 0 | 0 | 0 | 1 | 0 | 0 | 0 | 1 | 0 | 2 | 0 | 3 | 0 | 2 | 2 | 0 | 0 | 0 |
| Mitochondria | 20 | 3 | 4 | 17 | 15 | 46 | 94 | 75 | 104 | 99 | 111 | 120 | 0 | 0 | 0 | 2 | 3 | 2 | 25 | 14 | 27 | 9 | 14 | 22 |
| Nucleus | 0 | 1 | 0 | 1 | 0 | 0 | 2 | 1 | 1 | 1 | 0 | 1 | 0 | 0 | 0 | 0 | 1 | 2 | 0 | 0 | 0 | 0 | 0 | 0 |
| Nuclear Periphery | 0 | 0 | 0 | 0 | 0 | 0 | 1 | 1 | 1 | 1 | 1 | 0 | 0 | 0 | 1 | 0 | 1 | 0 | 0 | 0 | 0 | 1 | 1 | 1 |
| Nucleolus | 0 | 0 | 0 | 0 | 1 | 0 | 0 | 0 | 0 | 1 | 0 | 0 | 0 | 0 | 0 | 0 | 0 | 0 | 0 | 0 | 0 | 0 | 0 | 0 |
| Peroxisomes | 0 | 0 | 0 | 0 | 0 | 1 | 0 | 0 | 0 | 0 | 0 | 1 | 0 | 0 | 0 | 0 | 0 | 0 | 0 | 0 | 0 | 0 | 0 | 0 |
| SpindlePole | 0 | 0 | 0 | 0 | 0 | 1 | 0 | 1 | 0 | 0 | 0 | 0 | 0 | 0 | 0 | 2 | 0 | 2 | 1 | 0 | 0 | 0 | 1 | 1 |
| Vac/Vac Membrane | 2 | 0 | 1 | 4 | 4 | 4 | 6 | 3 | 7 | 2 | 2 | 7 | 3 | 3 | 0 | 20 | 17 | 22 | 5 | 29 | 8 | 2 | 7 | 17 |
| Unique Cell Count | 188 | 284 | 152 | 106 | 140 | 138 | 212 | 186 | 176 | 164 | 157 | 168 | 342 | 468 | 386 | 319 | 161 | 197 | 210 | 321 | 167 | 180 | 268 | 254 |
| Labelled Cell Count | 201 | 297 | 159 | 124 | 151 | 168 | 270 | 227 | 218 | 212 | 185 | 220 | 345 | 475 | 391 | 330 | 173 | 219 | 210 | 321 | 167 | 180 | 268 | 254 |
Yeast GFP Assignment
Protein Abundance
| Screen | WT1 | WT2 | WT3 | RAP60 | RAP140 | RAP220 | RAP300 | RAP380 | RAP460 | RAP540 | RAP620 | RAP700 | HU80 | HU120 | HU160 | rpd3Δ_1 | rpd3Δ_2 | rpd3Δ_3 | AF100 | AF140 | AF180 |
|---|---|---|---|---|---|---|---|---|---|---|---|---|---|---|---|---|---|---|---|---|---|
| Mean Cell GFP Intensity (1e-4) | 4.3 | 5.5 | 5.1 | 4.8 | 5.2 | 4.2 | 3.7 | 3.9 | 3.8 | 3.5 | 3.7 | 3.2 | 5.5 | 5.4 | 5.4 | 7.7 | 9.3 | 9.2 | 4.9 | 5.0 | 5.9 |
| Std Deviation (1e-4) | 0.5 | 1.0 | 0.9 | 1.3 | 2.0 | 1.1 | 1.2 | 1.2 | 1.5 | 2.3 | 1.4 | 0.9 | 1.1 | 1.4 | 1.4 | 1.6 | 2.0 | 1.8 | 1.3 | 1.3 | 1.5 |
| Intensity Change (Log2) | – | – | – | -0.1 | 0.03 | -0.27 | -0.46 | -0.39 | -0.44 | -0.54 | -0.46 | -0.66 | 0.1 | 0.08 | 0.09 | 0.59 | 0.87 | 0.85 | -0.06 | -0.02 | 0.2 |
Localization Change
| Localization | RAP60 | RAP140 | RAP220 | RAP300 | RAP380 | RAP460 | RAP540 | RAP620 | RAP700 | HU80 | HU120 | HU160 | rpd3Δ_1 | rpd3Δ_2 | rpd3Δ_3 |
|---|---|---|---|---|---|---|---|---|---|---|---|---|---|---|---|
| Cortical Patches | 0 | 0 | 0 | 0 | 0 | 0 | 0 | 0 | 0 | 0 | 0 | 0 | 0 | 0 | 0 |
| Bud | 0 | 0 | 0 | 0 | 0 | 0 | 0 | 0 | 0 | 0 | 0 | 0 | 0 | 0 | 0 |
| Bud Neck | 0 | 0 | 0 | 0 | 0 | 0 | 0 | 0 | 0 | 0 | 0 | 0 | 0 | 0 | 0 |
| Bud Site | 0 | 0 | 0 | 0 | 0 | 0 | 0 | 0 | 0 | 0 | 0 | 0 | 0 | 0 | 0 |
| Cell Periphery | 0 | 0 | 0 | 0 | 0 | 0 | 0 | 0 | 0 | 0 | 0 | 0 | 0 | 0 | 0 |
| Cytoplasm | -0.2 | -1.5 | -3.9 | -5.0 | -5.0 | -8.1 | -7.2 | -9.8 | -8.7 | 1.8 | 2.8 | 4.0 | -1.9 | -2.1 | -3.4 |
| Endoplasmic Reticulum | 0 | 0 | 0 | 0 | 0 | 0 | 0 | 0 | 0 | 0 | 0 | 0 | 0 | 0 | 0 |
| Endosome | 0 | 0 | 0 | 0 | 0 | 0 | 0 | 0 | 0 | 0 | 0 | 0 | 0 | 0 | 2.2 |
| Golgi | 0 | 0 | 0 | 0 | 0 | 0 | 0 | 0 | 0 | 0 | 0 | 0 | 0 | 0 | 0 |
| Mitochondria | 0 | 2.8 | 0 | 0 | 0 | 0 | 0 | 0 | 0 | 0 | 0 | 0 | 0 | 0 | 0 |
| Nucleus | 0 | 0 | 0 | 0 | 0 | 0 | 0 | 0 | 0 | 0 | 0 | 0 | 0 | 0 | 0 |
| Nuclear Periphery | 0 | 0 | 0 | 0 | 0 | 0 | 0 | 0 | 0 | 0 | 0 | 0 | 0 | 0 | 0 |
| Nucleolus | 0 | 0 | 0 | 0 | 0 | 0 | 0 | 0 | 0 | 0 | 0 | 0 | 0 | 0 | 0 |
| Peroxisomes | 0 | 0 | 0 | 0 | 0 | 0 | 0 | 0 | 0 | 0 | 0 | 0 | 0 | 0 | 0 |
| SpindlePole | 0 | 0 | 0 | 0 | 0 | 0 | 0 | 0 | 0 | 0 | 0 | 0 | 0 | 0 | 0 |
| Vacuole | 0 | 0 | 0 | 0 | 0 | 0 | 0 | 0 | 0 | 0 | 0 | 0 | 2.8 | 3.8 | 3.9 |
External localization resources
Images






























Protein Concentration and Protein Localization Data
| R1 | R2 | R3 | ||||||||||||||||
|---|---|---|---|---|---|---|---|---|---|---|---|---|---|---|---|---|---|---|
| G1 Pre-START | G1 Post-START | S/G2 | Metaphase | Anaphase | Telophase | G1 Pre-START | G1 Post-START | S/G2 | Metaphase | Anaphase | Telophase | G1 Pre-START | G1 Post-START | S/G2 | Metaphase | Anaphase | Telophase | |
| Concentration | – | – | – | – | – | – | – | – | – | – | – | – | – | – | – | – | – | – |
| Actin | 0.0065 | 0.0003 | 0.0329 | 0.001 | 0.0006 | 0.0003 | 0.0244 | 0.0073 | 0.0356 | 0.0116 | 0.0029 | 0.009 | 0.0162 | 0.0004 | 0.046 | 0.0179 | 0.0233 | 0.0002 |
| Bud | 0.0006 | 0.0001 | 0.0007 | 0.0004 | 0.0002 | 0 | 0.0042 | 0.0016 | 0.0021 | 0.0046 | 0.0006 | 0.0011 | 0.0005 | 0 | 0.0018 | 0.0454 | 0.0011 | 0.0003 |
| Bud Neck | 0.0002 | 0.0003 | 0.0024 | 0.0002 | 0.0004 | 0.0007 | 0.0018 | 0.0001 | 0.0008 | 0.0184 | 0.0009 | 0.0024 | 0.0318 | 0 | 0.0003 | 0.0004 | 0.0003 | 0.0003 |
| Bud Periphery | 0.001 | 0.0001 | 0.001 | 0.0005 | 0.0001 | 0 | 0.0046 | 0.0032 | 0.0034 | 0.009 | 0.0009 | 0.002 | 0.0003 | 0 | 0.0026 | 0.0666 | 0.0013 | 0.0001 |
| Bud Site | 0.0004 | 0.0035 | 0.0327 | 0.0002 | 0.0004 | 0 | 0.0328 | 0.0111 | 0.0094 | 0.0084 | 0.0015 | 0.0019 | 0.1366 | 0.0005 | 0.0066 | 0.0072 | 0.003 | 0 |
| Cell Periphery | 0.0006 | 0.0003 | 0.0011 | 0.0002 | 0.0001 | 0.0002 | 0.0019 | 0.0004 | 0.0006 | 0.0008 | 0.0002 | 0.0002 | 0.0007 | 0.0004 | 0.0005 | 0.0008 | 0.0001 | 0.0001 |
| Cytoplasm | 0.1251 | 0.3278 | 0.3333 | 0.3117 | 0.475 | 0.5155 | 0.2915 | 0.4007 | 0.3985 | 0.4367 | 0.2851 | 0.4437 | 0.0069 | 0.4282 | 0.1245 | 0.2291 | 0.2828 | 0.4794 |
| Cytoplasmic Foci | 0.0525 | 0.0121 | 0.0176 | 0.0144 | 0.0333 | 0.0118 | 0.0221 | 0.0098 | 0.0298 | 0.0222 | 0.0337 | 0.0164 | 0.5627 | 0.0088 | 0.0431 | 0.0211 | 0.0273 | 0.0168 |
| Eisosomes | 0.0004 | 0.0003 | 0.0006 | 0.0002 | 0 | 0.0001 | 0.0007 | 0.0002 | 0.0007 | 0.0002 | 0.0001 | 0.0001 | 0.0002 | 0 | 0.0009 | 0.0001 | 0.0002 | 0 |
| Endoplasmic Reticulum | 0.0087 | 0.0142 | 0.0159 | 0.0207 | 0.0105 | 0.0234 | 0.0089 | 0.0166 | 0.0057 | 0.0203 | 0.0049 | 0.0084 | 0.0002 | 0.0192 | 0.008 | 0.0224 | 0.0009 | 0.004 |
| Endosome | 0.0244 | 0.0104 | 0.0117 | 0.0435 | 0.0465 | 0.0112 | 0.0353 | 0.0074 | 0.0241 | 0.0526 | 0.0239 | 0.0079 | 0.0302 | 0.0056 | 0.0882 | 0.0199 | 0.0194 | 0.0037 |
| Golgi | 0.0027 | 0.0013 | 0.0042 | 0.0027 | 0.007 | 0.0003 | 0.0054 | 0.0025 | 0.0074 | 0.0264 | 0.0247 | 0.0035 | 0.0287 | 0.0005 | 0.0311 | 0.0009 | 0.0464 | 0.0002 |
| Lipid Particles | 0.0117 | 0.0012 | 0.003 | 0.0019 | 0.001 | 0.0009 | 0.0152 | 0.0009 | 0.0079 | 0.0223 | 0.0024 | 0.0027 | 0.0418 | 0.0006 | 0.0595 | 0.0009 | 0.0121 | 0.0002 |
| Mitochondria | 0.0045 | 0.0004 | 0.004 | 0.002 | 0.0016 | 0.0004 | 0.0058 | 0.0007 | 0.0068 | 0.0062 | 0.0668 | 0.009 | 0.0018 | 0.0001 | 0.0796 | 0.0014 | 0.0881 | 0.0001 |
| None | 0.6866 | 0.6197 | 0.5271 | 0.5869 | 0.3421 | 0.4302 | 0.4972 | 0.5311 | 0.4407 | 0.3264 | 0.5404 | 0.4828 | 0.0014 | 0.532 | 0.4249 | 0.5547 | 0.4651 | 0.489 |
| Nuclear Periphery | 0.034 | 0.0019 | 0.0023 | 0.0048 | 0.0274 | 0.001 | 0.0154 | 0.0016 | 0.0029 | 0.0066 | 0.0008 | 0.001 | 0.0001 | 0.001 | 0.0007 | 0.0021 | 0.0003 | 0.0005 |
| Nucleolus | 0.0004 | 0.0001 | 0.0003 | 0.0002 | 0.0008 | 0 | 0.0057 | 0.0001 | 0.0004 | 0.0007 | 0.0002 | 0.0001 | 0.001 | 0 | 0.0002 | 0.0007 | 0.0001 | 0.0001 |
| Nucleus | 0.0056 | 0.0011 | 0.0014 | 0.0014 | 0.026 | 0.0011 | 0.0071 | 0.0011 | 0.0014 | 0.0039 | 0.0011 | 0.001 | 0.0003 | 0.0005 | 0.0003 | 0.002 | 0.0005 | 0.0009 |
| Peroxisomes | 0.0146 | 0.0002 | 0.002 | 0.0004 | 0.0006 | 0.0001 | 0.0047 | 0.0004 | 0.0155 | 0.0064 | 0.004 | 0.0038 | 0.1324 | 0 | 0.0767 | 0.0005 | 0.0257 | 0.0001 |
| Punctate Nuclear | 0.005 | 0.0005 | 0.0012 | 0.0009 | 0.0233 | 0.0003 | 0.0091 | 0.0005 | 0.0022 | 0.0026 | 0.0006 | 0.0011 | 0.0048 | 0.0003 | 0.0008 | 0.0021 | 0.0005 | 0.0033 |
| Vacuole | 0.0064 | 0.0039 | 0.004 | 0.0044 | 0.0023 | 0.0022 | 0.0045 | 0.0024 | 0.0033 | 0.011 | 0.0035 | 0.0015 | 0.0012 | 0.0016 | 0.0027 | 0.0032 | 0.0007 | 0.0006 |
| Vacuole Periphery | 0.008 | 0.0003 | 0.0004 | 0.0016 | 0.0007 | 0.0003 | 0.0016 | 0.0002 | 0.0008 | 0.0027 | 0.0007 | 0.0003 | 0.0001 | 0.0001 | 0.0009 | 0.0004 | 0.0006 | 0.0001 |
Sequencing Data
| R1 | R2 | |||||||||
|---|---|---|---|---|---|---|---|---|---|---|
| G1 Post-START | S/G2 | Metaphase | Anaphase | Telophase | G1 Post-START | S/G2 | Metaphase | Anaphase | Telophase | |
| Gene Expression | 12.0941 | 12.7192 | 9.4382 | 13.1664 | 7.8402 | 7.8212 | 18.3261 | 15.4068 | 12.3465 | 15.3559 |
| Translational Efficiency | 1.1359 | 1.5317 | 1.7209 | 0.8297 | 1.5199 | 1.771 | 0.9435 | 1.0323 | 1.1277 | 1.064 |
Hit Data
| Dataset | Hit |
|---|---|
| Protein Concentration | – |
| Protein Localization | ✘ |
| Gene Expression | ✘ |
| Translational Efficiency | ✘ |
Endocytosis
| Temp | Actin Patch (Sac6-tdTomato) | Cortical Patch (Sla1-GFP) | Late Endosome (Snf7-GFP) | Vacuole (Vph1-GFP) |
|---|---|---|---|---|
| 37℃ | ||||
| RT |
Cell Cycle Omics
CYCLoPs (Anr2-GFP)
| Gene / Allele | Actin Patch (Sac6-tdTomato) | Cortical Patch (Sla1-GFP) | Late Endosome (Snf7-GFP) | Vacuole (Sac6-tdTomato) |
|---|
| Gene | Images |
|---|
| Gene | Images |
|---|
Images are not yet available
Images are not yet available